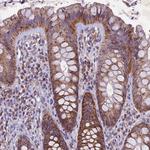
PMPCB Antibody in Immunohistochemistry (Paraffin) (IHC (P))

Search
Invitrogen
PMPCB Polyclonal Antibody
{{$productOrderCtrl.translations['antibody.pdp.commerceCard.promotion.promotions']}}
{{$productOrderCtrl.translations['antibody.pdp.commerceCard.promotion.viewpromo']}}
{{$productOrderCtrl.translations['antibody.pdp.commerceCard.promotion.promocode']}}: {{promo.promoCode}} {{promo.promoTitle}} {{promo.promoDescription}}. {{$productOrderCtrl.translations['antibody.pdp.commerceCard.promotion.learnmore']}}
产品信息
PA5-59246
种属反应
宿主/亚型
分类
类型
抗原
偶联物
形式
浓度
规格
纯化类型
保存液
内含物
保存条件
运输条件
RRID
产品详细信息
Immunogen sequence: WGFSESLLIR GAAGRSLYFG ENRLRSTQAA TQVVLNVPET RVTCLESGLR VASEDSGLST CTVGLWIDAG
Highest antigen sequence identity to the following orthologs: Mouse - 79%, Rat - 77%.
靶标信息
PMPCB is a member of the peptidase M16 family and encodes a protein with a zinc-binding motif. This protein is located in the mitochondrial matrix and catalyzes the cleavage of the leader peptides of precursor proteins newly imported into the mitochondria, though it only functions as part of a heterodimeric complex.
仅用于科研。不用于诊断过程。未经明确授权不得转售。
篇参考文献 (0)
生物信息学
蛋白别名: Beta-MPP; mitochondrial processing peptidase beta subunit; Mitochondrial-processing peptidase subunit beta; P-52; peptidase (mitochondrial processing) beta; peptidase, mitochondrial processing beta subunit; unnamed protein product
基因别名: Beta-MPP; MAS1; MPP11; MPPB; MPPP52; P-52; PMPCB
UniProt ID: (Human) O75439
Entrez Gene ID: (Human) 9512